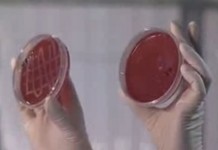

Архив
Обезболивающие средства: что уточнить у врача?
Какую дозу лекарства я должен принимать? Как часто? Если препарат не помогает, и боли продолжаются, могу ли...
Что сказать в утешение
Непросто найти верные слова, чтобы утешить убитого горем друга или коллегу. Иногда сказанное из лучших побуждений может расстроить еще сильнее. Психологи в этом случае...
Новое оружие против прыщей
Подросткам с тяжелой формой угревой сыпи обычные методы лечения не помогают. Совсем недавно у дерматологов появилось новое оружие против прыщей. Как оно действует, и каких результатов удается добиться благодаря его применению?
Современный метод лечения прыщей
Главная причина подростковых прыщей - повышенная выработка кожного сала. Именно в нем развиваются микробы, вызывающие воспаление и появление прыщей. Избавить подростка от прыщей можно с помощью современного лекарственного препарата.
Как избавиться от черных точек
Черные точки образуются вследствие закупоривания сальных желез лица излишками кожного сала, отмершими клетками кожи и мелкими частичками пыли. Избавиться от них можно с помощью специальной маски.
Правила умывания
Подростковые прыщи - результат гормональной перестройки организма. О том, как правильно ухаживать за кожей лица, покрытой прыщами, расскажет профессор Аравийская Е. А.
Революционный метод лечения прыщей
Олег и Оксана уже много лет безуспешно борются с прыщами на лице. Сегодня они станут участниками уникального эксперимента. Под руководством главного дерматолога
Новый метод борьбы с прыщами
Появился новый метод борьбы с подростковыми прыщами. Его действие испытал на себе Александр. Он прошел курс лечения и готов рассказать о результатах.
Таблетка от прыщей
За последние несколько лет произошел прорыв в лечении тяжелых форм угревой сыпи. Появилась таблетка, которая избавляет подростков от прыщей. О результатах клинических исследований нового метода лечения расскажет главный дерматолог
Новый метод лечения прыщей
Прыщи – одна из главных проблем подростков. До сих пор трудно поддавалась лечению третья – самая тяжелая степень тяжести прыщей. Сегодня в арсенале врачей-дерматологов появился новый метод лечения подростковых прыщей.